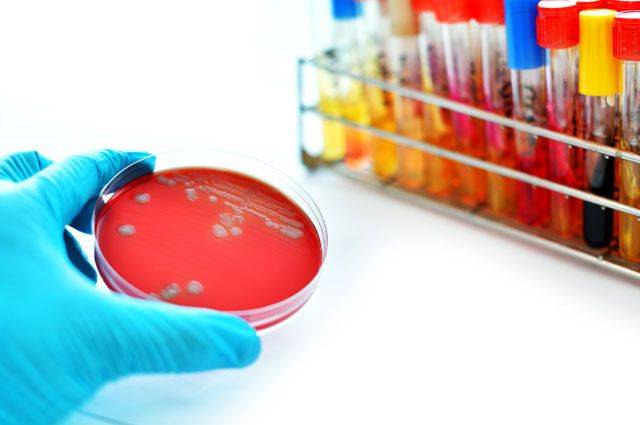
Как ученые готовятся к миру без антибиотиков? - hi-news.ru
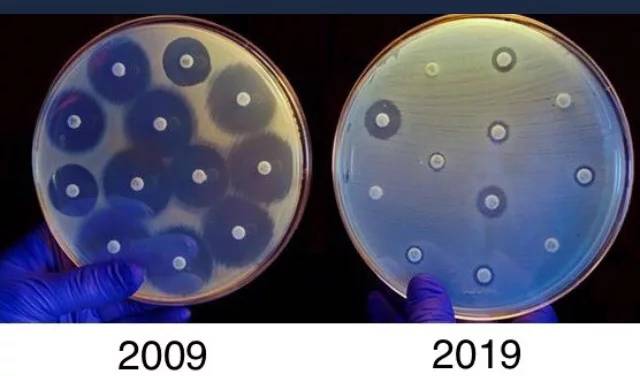
Вред от антибиотиков

Бактерии – польза или вред? Выполнила: ученица 2-Б класса ХГ 116 Воронина Алиса. – презентация
1 Бактерии – польза или вред? Выполнила: ученица 2-Б класса ХГ 116 Воронина Алиса
2 Почему люди болеют? Да потому, что везде есть бактерии, которые вызывают различные болезни! Сейчас я подробно расскажу, кто такие бактерии.
3 Бактерии – это очень и очень маленькие одноклеточные организмы. Для того, чтобы их увидеть, нам нужен специальный прибор – микроскоп, который увеличивает предметы в сотни раз.
5 Бактерии находятся везде. Они есть в почве, воде, еде, воздухе, дожде… Микробиологи наших дней доказали, что нет ни одного уголка на земном шаре, где бы не встречались микробы.
6 Их находят в глубинах мирового океана, в верхних слоях атмосферы, в почве, на всех окружающих нас предметах, в домах, на улице. Бактерии живут в животных и даже в каждом из нас.
7 Если бы не было бактерий, на Земле не было бы никакой жизни. Был бы один песок, как на Луне.
Важно
8 Бактерии появились много лет назад Сначала образовалась Земля, возникли кислород и водород. Около 3,5 миллиардов лет назад появились первые крохотные бактерии и водоросли.
9 И только 700 миллионов лет назад в море появились первые животные – черви и медузы.
10 Бактерии помогают перегнивать листьям, упавшим на землю. Участвуют в образовании полезных ископаемых, поддерживают запасы углекислого газа и кислорода в атмосфере.
11 Болезни, вызываемые микробами, преследуют человека очень давно На фреске храма, построенного более 3500 лет тому назад в столице Древнего Египта Мемфисе, изображен жрец с характерным признаком полиомиелита – атрофией мышц на укороченной ноге.
12 Один тип микробов вызывает только одно заболевание. Например, микробы, вызывающие скарлатину, не приведут к заболеванию малярией или другой болезнью.
13 Однако существует множество микробов которые приносят человеку пользу. Тысячелетиями человек использовал молочные бактерии для создания многих молочных продуктов. Если в молоко добавить разные бактерии, получатся сыр, простокваша, кефир, йогурт, творог.
14 Бактерии помогают животным – антилопам, коровам лосям, козам, лошадям – переваривать растительную пищу.
15 Человек состоит из человеческих клеток, а также бактериальных, грибковых и вирусных форм жизни. В теле человека несколько триллионов клеток и более 100 триллионов бактерий, их насчитывается 500 видов.
Совет
16 Из двух килограммов микроорганизмов, которые проживают в человеческом теле, один обитает в кишечнике. Но наряду с опасными для человека бактериями есть множество таких, без которых человек погибнет.
17 В кишечнике японцев есть особый вид бактерий, которого нет у других жителей планеты. Именно он помогает хорошо перерабатывать различные виды морепродуктов.
18 «Добрые» микробы пробиотики – повышают иммунитет против гриппа. Опасных бактерий, которые вызывают разные болезни, очень много в общественных местах – на дверных ручках, тележках в магазине, компьютерных мышках, поручнях в автобусе…
19 Вредных бактерий много на фруктах и ягодах, которые растут на улице. Одной бактерии может быть достаточно, чтобы человек заболел. Поэтому необходимо регулярно мыть руки с мылом, овощи и фрукты перед едой!
Врачи отмечают, что фотофармакология представляет собой перспективное направление в медицине, которое сочетает в себе элементы фототерапии и фармакологии. Специалисты подчеркивают, что использование света для активации лекарственных веществ может значительно повысить эффективность лечения различных заболеваний. Например, в онкологии фотодинамическая терапия уже зарекомендовала себя как метод, позволяющий целенаправленно уничтожать раковые клетки, минимизируя при этом повреждение здоровых тканей.
Медики также акцентируют внимание на необходимости дальнейших исследований в этой области, чтобы полностью раскрыть потенциал фотоактивных препаратов. Они считают, что интеграция фотофармакологии в клиническую практику может привести к новым подходам в лечении хронических заболеваний, таких как псориаз и экзема. Однако врачи предупреждают о важности соблюдения строгих протоколов и стандартов безопасности, чтобы избежать возможных побочных эффектов. Таким образом, фотофармакология открывает новые горизонты, но требует тщательного изучения и контроля.

Уничтожить супербактерии — смогут суперантибиотики
Что предпринимается в этом направлении?
Применяются методы:
- молекулярной биологии;
- медицинской химии;
- генетики и других соответствующих дисциплин.
Последние достижения
2016, 2017,2018 — годы открытия мощных антибиотиков.
1. Умный ванкомицин
Более полувека медикаментозное средство эффективно применялся против большинства вредоносных патогенов. Но появились резистентные штаммы.
Ученые-исследователи института Скриппса произвели молекулярные преобразования, которые увеличили его мощь тысячекратно, сделали его умнее.
Теперь антипатоген располагает тремя действующими силами: если бактерия, выработавшая устойчивость к ванкомицину, устоит против одной из них, две другие завершат процесс, уничтожив патоген.
Однако пока эта версия препарата находится в лаборатории.
Ученые ищут пути удешевления и упрощения ее производства. Но при этом настаивают, что лекарство должно выпускаться, при любых обстоятельствах, так как способно спасти множество жизней.
2. Параллельно идут работы над технологиями редактирования гена CRISPR в целях противостояния инфекциям.
3. Уникальный алгоритм VarQuest
Начало 2018 отмечено сообщением о том, что российскими биологами из Центра биотехнологии СПбГУ в сотрудничестве с американским ученым Х. Мохимани был разработан алгоритм VarQuest, который основательно форсирует открытие новейших версий известных антибактериальных средств.
В течение часа он обнаружил в 10 раз более вариаций, чем все предыдущие исследования данной области.
Найдено более тысячи вариантов препаратов, паттернов, которые традиционными методами не были бы обнаружены.
По утверждению Мохимани, для такого объема результатов изысканий потребовались бы столетия.
4. Разработан принципиально новый класс антибиотиков против супербактерий
Простые бактерициды (пенициллин) легко справляются с грамположительными бактериями, атакуя белок пептидогликан, расположенный на внешней мембране, проникая внутрь клетки и убивая ее.
Однако супербактерии относятся большей частью к типу грамотрицательных, имеющих более сложное строение. Белок микроорганизма заключен между двух мембран, которые также очередь защищены дополнительным слоем липополисахаридов.
Уже созданы суперантибиотики, способные бороться с такими супербактериями, которые пробиваясь через стенки клеток, блокируют жизненно необходимые ферменты бактерий.
Они относятся к классу ариломицины.
Стало известно, что в сентябре 2018г., продолжая работать над реконструкцией химических характеристик ариломицина, ученые получили инновационную молекулу G0775.
Такого рода антипатогены открываются очень редко!
Во главе исследовательских работ стоит датский ученый доктор Г.Х. Грэм.
Модифицированный антипатоген:
- Значительно результативнее первоначального;
- Легко проникает через мембрану клеток особо опасных бактерий, к примеру, успешно справляется со штаммом бактерии Klebsiella pneumoniae, обладающим резистентностью к 13 антибактериальным медикаментам.
Но, несмотря на отменные позитивные результаты, до производства нового лекарственного средства еще далеко.
Руководитель исследований заявил, что продолжаются работы по модификации G0775, цель которых — уничтожения прочих, не поддающихся имеющимся препаратам штаммов бактерий.
Фотофармакология — это относительно новая область науки, которая привлекает внимание как исследователей, так и практикующих врачей. Многие специалисты отмечают, что использование света для активации лекарственных веществ открывает новые горизонты в лечении различных заболеваний. Например, некоторые пациенты делятся положительными отзывами о терапии, основанной на этом подходе, отмечая улучшение состояния при минимальных побочных эффектах. Однако не все так однозначно: некоторые эксперты выражают осторожность, подчеркивая необходимость дополнительных исследований для подтверждения эффективности и безопасности методов. В целом, интерес к фотофармакологии растет, и многие надеются на ее дальнейшее развитие, которое может привести к революционным изменениям в медицине.

Есть ли альтернатива антибиотикам?
При всей важности, неоценимой пользе эти медикаменты не являются панацеей. Необходимы, допустимы и уже появляются другие методы терапии
Антибиотики в молоке
Использование антибиотиков при лечении мастита создало проблемы для переработчика молока и потребителя.
Исследования показали, что пенициллин был основным антибиотиком, обнаруженным в молоке. Пенициллин в очень малых концентрациях, обнаруженный в молоке, может вызывать реакции у высокочувствительных людей.
Неправильное использование антибиотиков для борьбы с маститом является основной причиной их попадания в молоко.
Антибиотики в молоке относительно устойчивы к температурам пастеризации и выше, а также к низким температурам (-12 градусов).
Многие лекарства хранятся в организме животного в течение более длительного времени, чем указано на этикетке. Следовательно, образцы молока остаются положительными на остатки антибиотиков.
Хорошим примером является пенициллин, который якобы исчезает из молока за 72 часа. Тем не менее, остаток пенициллина сохраняется в молоке в течение 18 дней.
По истечении времени, указанного на этикетке, остатки лекарственного средства обнаружили у 35% коров, получавших цефапирин от мастита, и у 27% коров, получавших внутримышечные инъекции пенициллина.

Вред организму от антибиотиков в пищевых продуктах:
- передача устойчивых к антибиотикам бактерий человеку
- иммунопатологические эффекты
- аутоиммунная реакция
- канцерогенность
- мутагенность — нефропатия
- репродуктивные расстройства
- токсичность для костного мозга
- аллергия
Мы проигрываем бактериям
Как и все живое в этом мире, бактерии стремятся выжить, поэтому со временем приспосабливаются к любым условиям, в которых оказываются. Между одинаковыми, на первый взгляд, бактериями, вызывающими одну и ту же болезнь, могут существовать незначительные генетические различия, которые могут сделать какие-то из них более чувствительными к тем или иным лекарственным препаратам, а других — менее подверженными такому воздействию..В итоге более восприимчивые бактерии погибают первыми, а менее восприимчивые способны выжить, размножиться, и в результате произвести на свет новое поколение особей, способных лучше сопротивляться антибиотикам. Проще говоря, идёт процесс эволюции, нравится это человечеству или нет.
фото с сайта okeydoc.ru
Хуже того, люди часто сами помогают бактериям приспосабливаться. Каждый из нас слышал, что принимать антибиотики без назначения врача нельзя. Каждый врач хорошо знает, что нельзя постоянно назначать одному пациенту один и тот же антибиотик. Тем не менее человеческое легкомыслие и расчет на то, что на этот раз все обойдётся, нередко подталкивает нас к простым, на первый взгляд решениям: самому назначать себе уже ранее испробованные лекарства, которые вроде бы хорошо помогли в предыдущий раз.. В результате мы сами в себе выращиваем поколение болезнетворных супер-бактерий, которым не страшны никакие антибактериальные препараты.
Самая живучая и распространённая “супер-бактерия” — это метициллино-устойчивый золотистый стафилококк. Многие десятилетия бороться с этим, постоянно мутирующим штаммом, было практически невозможно, пока не были разработаны принципиально новые методы лечения.
Так же быстро становятся устойчивыми к лекарствам бактерии, живущие в кишечнике, и возбудители гонореи. А один из самых страшных примеров устойчивых к лекарствам бактерий — это пресловутая палочка Коха, продуцирующая тяжёлые и даже неизлечимые формы туберкулёза
Фармацевтическая промышленность и медицинские лаборатории едва успевают разработать и произвести новый антибактериальный препарат, как его эффективность уже резко снижается. Примерно через год вылечить инфекцию одним только этим препаратом становится невозможно, а через два – антибиотик практически перестает помогать.
Более того, последние исследования показывают, что некоторые бактерии научились даже питаться антибиотиками и с их помощью быстрее растут и размножаются. Исследования проводились на одном из видов болезнетворной кишечной палочки, которая вызывает у людей боли в желудке, диарею и почечную недостаточность. Колонию этих бактерий в течение 4 дней обрабатывали одним и тем же антибиотиком. И за это время палочки не только научились сопротивляться лекарству, но и в его присутствии стали быстрее размножаться – после окончания эксперимента размер колонии бактерий стал в три раза больше.
Это значит, что сегодня даже самые современные лекарства не работают, как задумано. Эффективность антибиотиков стала намного ниже, чем мы себе это представляли прежде. Между тем вера в могущество антибактериальных препаратов живёт в народе и регулярно приводит к многочисленным человеческим жертвам во время участившихся и ставших более сильными эпидемий, с которыми прежде медики легко справлялись.
Поэтому в развитых странах все больше врачей обращают внимание на альтернативные способы борьбы с бактериями, сокращая применение антибиотиков до минимума
Прямая атака
Иногда, впрочем, полумеры не помогают. Существуют альтернативы традиционным антибиотикам, которые могут убивать бактерий. Одна из стратегий — создать искусственные версии антимикробных пептидов (АМП), которые являются частью врожденного иммунного ответа у микробов, растений и животных (вроде тасманийских дьяволов). Эти компоненты атакуют мембрану патогена и сеют хаос внутри клетки.
В рамках недавно проведенного проекта, де ла Фуэнте сотрудничал с Лу и другими, чтобы выбрать нетоксичный АМП, обнаруженный у простых морских животных, называемых оболочниками. Ученые добавили несколько аминокислот к основной настройке, улучшив ее способность лечить мышей, инфицированных устойчивыми к антибиотикам штаммами кишечной палочки или MRSA. Укрепленный АМП также укрепляет иммунную систему грызунов, уменьшает воспаление и призывает помощь в форме белых кровяных клеток.
Антимикробные пептиды могут победить широкий спектр патогенов, и бактерии с трудом вырабатывают устойчивость к ним. «По сравнению с обычными антибиотиками, эти пептиды более эффективны во многих случаях», говорит де ла Фуэнте.
АМП состоят из относительно коротких цепочек аминокислот, строительных блоков белка. Поэтому их довольно просто (хотя и дорого) строить. «Нам еще предстоит снизить стоимость», говорит де ла Фуэнте. Ученые изучают способы создания АМП более дешевым путем программирования микробов, чтобы не полагаться на машину и позволить микробам делать все самостоятельно.
Тем не менее существуют опасения, что АМП может накинуться на клетки носителя. И как со многими альтернативами антибиотиков, отправить пептиды в нужное место в достаточно высокой концентрации, чтобы сохранить эффективность, может быть проблемой. В краткосрочной перспективе более вероятно локальное применение, считает де ла Фуэнте. Эти пептиды можно было бы включить, например, в крем, который можно было бы применить на открытую рану или на место поражения кожи инфекцией. Также их можно было бы использовать для покрытия столов, компьютеров, хирургических инструментов или катетеров, чтобы препятствовать появлению колоний микробов на них.
Виды и особенности
Множество видов антибактериальных препаратов стало причиной создания системы классифицирования их на группы. В зависимости от того, какое действие проявляет препарат после взаимодействия с бактериальной клеткой, различают две основных группы препаратов:
- Бактериостатические – медикаменты препятствуют размножению микробов, после чего не убивают их.
- Бактерицидные – уничтожают микробов, после чего способствуют их выведению из макроорганизма.
Согласно химическому составу в медицине широко применяется следующая классификация:
- Бета-лактамные препараты: пенициллины (синтезируются Penicillinum рода плесневых грибков) и цефалоспорины (по структуре довольно похожи на пенициллины, применяются после предыдущих, если есть устойчивость бактерий к пенициллинам).
- Макролиды – имеют бактериостатическое действие и сложную структуру.
- Тетрациклины – оказывают, как правило, бактериостатическое действие, применяются в лечении заболеваний инфекционного генеза мочевыводящей (микробы в моче) и дыхательной систем; также ими лечат тяжелые инфекционные заболевания: туляремию, сибирскую язву, бруцеллез.
- Аминогликозиды – высокотоксичные бактерицидные препараты, используются в лечении тяжелых инфекционных осложнений: перитонита, сепсиса.
- Левомицетины – бактериостатические препараты, применяются редко, так как после их использования могут развиваться угрожающие жизни осложнения: поражение структуры и нарушение кровеобразующей функции костного мозга.
- Гликопептидные антибиотики – препятствуют образованию стенки бактериальной клетки, обладают бактерицидным эффектом, однако против энтерококков, стафилококков и стрептококков проявляют бактериостатическое действие.
- Линкозамиды – обладают бактериостатическими свойствами (вследствие блокировки продуцирования рибосомами белка). Высокие концентрации на высокочувствительные микробы могут действовать бактерицидно.
- Противотуберкулезные медикаменты – высокоэффективны против туберкулезной палочки: изониазид, салюзид, фтивазид, метазид, протионамид, этионамид.
- Противолепрозные средства – наиболее эффективны против возбудителей лепры: солюсульфон, диафенилсульфон, диуцифон.
- Антибиотики различных групповых принадлежностей – к ним относят ристомицина сульфат, рифамицин, фузинид-натрий, гелиомицин, грамицидин.
- Антибиотики противогрибковой направленности действия – обладают литическим действием против грибков, повреждают клеточную мембрану грибков, после чего провоцируют их гибель. Такими препаратами лечат грибковые поражения кожи, ногтей и другие патологии.
Бактерии vs. Человечество: глобальное сопротивление
Случайное открытие Флеминга ознаменовало начало новой эры в медицине. Человечество смогло побороть множество смертельных бактериальных заболеваний, которые на протяжении тысячелетий оставались неизлечимыми.
Но наряду с возможностями антибиотиков, Флеминг обнаружил и другое – при недостаточном количестве пенициллина или если его действие было непродолжительным, бактерии приобретали устойчивость к антибиотику. Флеминг об этом рассказывал в своих выступлениях по всему миру и не раз предупреждал, что не стоит использовать пенициллин, пока заболевание не будет диагностировано, а при необходимости применения антибиотика, его нельзя использовать в течение короткого времени и в совсем малых количествах. К сожалению, это предостережение не помогло.
Уже к 1945 году пенициллин стал доступен повсеместно, активно создавались и другие антибиотики. На протяжении последующих десятилетий они применялись практически бесконтрольно. К примеру, одной из проблем стало самолечение антибиотиками среди населения. Причем при самостоятельном выборе антибиотика часто предпочтение отдавалось именно препаратам широкого спектра действия. Антибиотики стали также широко применяться в сельском хозяйстве – до 80% всех антибиотиков в мире используют для лечения скота. Все это ускорило темпы формирования «антибиотикорезистентности» (от английского resist – «сопротивляться») и привело к тому, что многие инфекционные заболевания снова стали неизлечимы.
Легионеллы – патогенные грамотрицательные бактерии
«Все хотят жить, в том числе и микробы, – рассказывает РИА «Новый день» доктор медицинских наук Тамара Перепанова. – Они развивают сопротивляемость. И эта борьба складывается в пользу микроорганизмов. Они вырабатывают новые штаммы быстрее, чем все фармакологии мира разрабатывают новые препараты. И вот уже антибиотик неэффективен». К слову, самый первый антибиотик – пенициллин – практически бесполезен сегодня: у бактерий к нему развилась почти полная устойчивость.
В 2017 году Всемирная организация здравоохранения (ВОЗ) впервые опубликовала список устойчивых к действию антибиотиков «приоритетных патогенов» – 12 видов бактерий, представляющих наибольшую угрозу для здоровья человека. В их числе – Acinetobacter baumannii, Pseudomonas aeruginosa, Enterobacteriaceae, Enterococcus faecium, Staphylococcus aureus, Helicobacter pylori, Campylobacter spp., Salmonellae, Neisseria gonorrhoeae, Streptococcus pneumoniae, Haemophilus influenzae, Shigella. За всеми этими названиями – очень серьезные заболевания: сепсис, менингит, пневмония, брюшной тиф, дизентерия и другие.
По данным ВОЗ практически все существующие патогенные для человека бактерии приобретут устойчивость к антибиотикам уже через 10-20 лет. По прогнозам, к 2050 году число жертв бактериальных инфекций возрастет до 10 млн в год. Кстати, с уверенностью можно констатировать, что для любого жителя нашей страны вероятность подцепить бактериальную инфекцию, устойчивую ко всем основным антибиотикам, сейчас гораздо выше, чем заразиться вирусом из Китая.
Растения — натуральные антибиотики
Тысячелистник, багульник, пижма: подавляют размножение белого стафилококка и энтеробактерий. Багульник и пижма подавляют размножение кишечной палочки, а тысячелистник убивает её. Пижма убивает микрококки.
Подорожник действует как и пижма, а также убивает белый стафилококк и кишечную палочку.
Полынь горькая убивает кишечную палочку, подавляет размножение синегнойной палочки.
Пустырник и элеутерококк подавляют размножение белого стафилококка, протея, кишечной палочки и энтеробактерий. Убивает кишечную палочку.
Календула, чистотел, шалфей и эвкалипт оказывают бактерицидное действие на стрептококки и стафилококки. Эвкалипт убивает и пневмококки.
Вред антибиотиков при беременности
Микрофлора оказывает влияние на здоровье матери и ребенка, включая нормальную иммунную и метаболическую функцию в более позднем возрасте. Применение антибиотиков во время беременности, несомненно, влияет на бактериальную среду матери и плода.
Лечение антибиотиками во время беременности широко распространено в западных странах и составляет 80% от назначенных лекарств при беременности. Однако лечение антибиотиками, хотя иногда и спасает жизни, также может иметь пагубные последствия.
У беременных женщин введение антибиотиков во время беременности приводит к изменениям во влагалищном микробиоме до рождения, что оказывает долговременное влияние на раннюю микробную колонизацию новорожденного и имеет связь с детским ожирением.
Более недавнее исследование, опубликованное в 2008 году, продемонстрировало, что назначение антибиотиков женщинам при спонтанных преждевременных родах с неповрежденными мембранами было связано с повышенным риском развития церебрального паралича и функциональных нарушений у их детей в возрасте 7 лет.
Применение антибиотиков во время беременности также было связано с повышенным риском развития астмы в раннем детстве, повышенный риск детской эпилепсии, а также повышенный риск ожирения в детском возрасте.
Конечно, можно утверждать, что первичная материнская инфекция была причиной повышенного риска этих состояний, а не самого лечения. Тем не менее, мы предполагаем, что антибиотики во время беременности могут влиять на бактериальную экосистему матери, а также на плод, и, следовательно, что их использование должно быть тщательно продумано, основываясь на том, что известно, и что остается неизвестным относительно их воздействия.
Антибиотики при беременности следует применять только по назначению, выбирая те из них, которые имеют самый узкий диапазон.
Как бактерии приобретают устойчивость?
Антибиотики помогают при лечении инфекций, пока на бактерии есть «мишени» для действия препарата. «Мишенью» может быть компонент клеточной стенки или какой-либо фермент, участвующий во внутриклеточных процессах бактерии. Эффективность антибактериального лечения снижается по нескольким причинам.
Мутация
На клеточной стенке возбудителей существуют так называемые пенициллинсвязывающие белки. Они участвуют в процессе образования клеточной стенки микробов. Именно эти белки являются «мишенью» для действия антибиотика.
В процессе эволюции бактерии мутируют, а структура белка изменяется. Чем сильнее отличается новый белок от старого, тем менее эффективно антибактериальное лечение.
Бактерии научились удалять препарат
Даже проникнув внутрь клетки, антибиотик может не подействовать. В бактериях есть транспортные белки, которые выводят все препараты из клетки, как наш организм, например, удаляет вредные вещества через почки. Это явление у микробов называется эффлюксом или активным выведением.
Бактерии перешли в атаку
Чтобы высокие дозы антибиотика не могли разрушить и даже замедлить рост бактерий, последние стали выделять токсины в ответ. Например, чтобы пенициллин не нарушал процесс сборки бактериальной стенки, микробы продуцируют бета-лактамазу. Этот фермент связывается с пенициллином и инактивирует его.
Микробы установили «фейсконтроль»
Многие антибиотики действуют не на клеточную стенку бактерий, а на ее внутренние процессы. Чтобы проявить свой противомикробный эффект, молекула препарата должна проникнуть через мембрану возбудителя. Обычно антибиотики проникают прямо через стенку микроба. Но существует особая группа бактерий, у которых есть дополнительный защитный слой в стенке – липополисахаридные «трубочки». Антибиотик не может преодолеть этот слой, поэтому направляется к порам, через которые в клетку бактерии попадают питательные вещества и выделяются продукты ее жизнедеятельности. Многие микробы научились суживать эти коридоры, чтобы крупные молекулы антибиотика не могли пройти внутрь.
Бактерии нашли другой способ питания
Некоторые антибактериальные средства «притворяются» химическим соединением, которое необходимо микробам для обмена веществ. Проникая внутрь клетки под видом «стройматериала», антибиотик встраивается в ее метаболизм. Но из-за «диверсанта» бактерии собирают свои белки неправильно, что приводит к гибели возбудителей. Если микроб находит новый источник питания, он перестает реагировать на антибиотик, который был похож на его «еду».
Обмен опытом
Способность не поддаваться действию антибиотиков сохраняется в геноме бактерии в виде гена резистентности или r-гена. R-ген передается всем потомкам выжившей бактерии после ее деления. Но оказалось, что информацию о том, как победить лекарство, бактерия передает не только дочерним клеткам, но и своим «соседям». Между двумя микробами образуется «мостик», через который переходит плазмид – переносчик фрагмента ДНК бактерии. Благодаря такой взаимной поддержке микробов мы можем столкнуться с проблемой тотальной устойчивости.
Как работают антибиотики
Когда вы принимаете антибиотик, он попадает в ваш кровоток и проходит через ваше тело, убивая бактерии. Однако существует мало различий между вредными и хорошими бактериями. Антибиотики убивают не только вредные бактерии, от которых вы заболели, но и бактерии, которые приносят вам пользу.
Хорошие бактерии в кишечнике помогают людям разными способами, в том числе помогают вырабатывать витамины и повышают иммунитет. Некоторые исследователи считают, что уничтожение их антибиотиками может способствовать росту хронических заболеваний, таких как ожирение, астма и рак.
Кроме того, потеря хороших бактерий может дать возможность размножаться другим типам бактерий, что приводит к оппортунистической инфекции.
Иногда оппортунистическая инфекция возникает, когда бактерии из окружающей среды попадают в ваш организм и поражают бактерии, поврежденные антибиотиком. В других случаях оппортунистическая инфекция начинается, когда антибиотики нарушают баланс микроорганизмов, проживающих у вас, и обычно дружественные бактерии размножаются слишком быстро и становятся вредными.
Антибиотики убивают только бактерии
Как бы ни старался уважаемый доктор Комаровский, а воз и ныне там: процент людей, которые понимают разницу между вирусом и бактерией все так же низок. Даже когда вопрос идет о родителях, которые ответственны уже не только за свою жизнь, но и за здоровье своего ребенка, знание такого рода встречается редко. Вот и едят дети таблетки тогда, когда требуется терпение, обильное теплое питье и правильный воздух.
Немного из курса биологии: бактерия — это микроорганизмы, чаще всего одноклеточные. Это полноценные, настоящие клетки, живой организм им нужен как «дом» с шикарным буфетом для будущих поколений. Не все бактерии «плохие», некоторые помогает нам готовить, например, вино или йогурты. Вирус — это примитивная форма жизни, которая не умеет существовать вне живого организма. Вопросы о самостоятельном питании, размножении и даже существовании не стоят.
Будет ли работать антибиотик с вирусом? Конечно же, нет. Вирусы слишком примитивны, и на сегодняшний момент нет лекарственных средств, которые бы успешно боролись с вирусными заболеваниями.
Многие спрашивают как же отличить одно от второго? Если вы по какой-то причине не доверяете своему доктору (даже после того, как он взял у вас анализы), вот краткий список болезней, вызываемых бактериями и вирусами:
- вирусные заболевания: ОРВИ (включая грипп), герпес, вирусные гепатиты, детские болезни (корь, краснуха, паротит), ВИЧ, оспа, в подавляюзем числе случаев бронхит и другие.
- бактериальные: туберкулез, многие венерические заболевания (например, сифилис, гонорея, хламидиоз), холера, тиф, столбняк, коклюш, дифтерия и прочие.
Итак, вывод: при острых респираторных инфекциях антибиотики ребенку (и взрослому тоже) не нужны. Вирусные инфекции обычно проходят сами по себе за 1–2 недели. Даже некоторые ушные бактериальные инфекции могут исчезнуть без лечения. Если вашему крохе не выписали антибиотик, то уточните, какие средства можно использовать для снятия неприятных симптомов.
Когда мед и малина не помогают при лечении
Начнем с того, что некоторые заболевания могут излечиваться только с применением антибиотиков. И лучше не затягивать с их приемом, полагаясь лишь на народные средства и аспирин, а то дождетесь, что самочувствие малыша начнет ухудшаться. Одним словом, не стоит чересчур нервничать, если пришедший на вызов доктор назначит вашему ребенку такой лекарственный препарат.
При этом надо иметь в виду, что лечение детей с помощью антибиотиков может назначаться и проводиться только педиатром. Никакие самостоятельные «назначения» по совету подруг и соседок тут неприемлемы.
Микрофлора уцелеет
Так что же такое антибиотики и на самом ли деле они «против всего живого»? В действительности антибиотики предназначены для того, чтобы подавлять образование и размножение бактерий. Они борются не с вирусами, а именно с бактериями. Если у ребенка инфекция вирусная, то не следует сразу прибегать к антибиотикам, если же она бактериальная, то их применение уместно и даже необходимо.
Что мы должны знать об антибиотиках
Между тем, антибиотики бывают разными. Некоторые препараты, узкоцелевой направленности, борются с определенными заболеваниями, подавляя конкретные бактерии. А некоторые, помимо лечебного эффекта, оказывают на организм не совсем благоприятное побочное действие, уничтожая вместе с бактериями-вредителями и полезные бактерии, в частности, микрофлоры кишечника. Но как показывают последние медицинские исследования, антибиотики влияют на каждый организм по-разному, и нарушения в работе желудочно-кишечного тракта после их приема возникают далеко не у всех пациентов. Кроме того, сегодня вместе с антибиотиками врачи назначают сопутствующие препараты, содержащие полезные бактерии и оказывающие поддержку кишечной микрофлоре.
В соответствии с инструкциями
Итак, как же надо давать ребенку антибиотики? На самом деле, не только детям, но и взрослым можно принимать антибиотики исключительно по назначению врача. И покупать в аптеке надо только те препараты, которые назначены доктором, а в случае их отсутствия ни в коем случае не заменять их самостоятельно на другие. Никакой самодеятельности и произвольных манипуляций с их дозировкой тоже не допускается – позволительны только те дозы, которые обозначил врач. Он же определяет и длительность лечения.
Что мы должны знать об антибиотиках
Ни в коем случае не прерывайте прием по собственному решению. Допустим, после нескольких дней приема антибиотика вашему ребенку заметно полегчало, и вы решили, что он уже вылечился, что можно прекратить лекарственную нагрузку на организм. Между тем, вы должны иметь в виду, что если курс приема не закончен, то оставшиеся в живых бактерии вскоре снова размножатся и начнут новую атаку на организм. Возобновление приема старого антибиотика будет при этом уже неэффективным, так как у бактерий выработалась по отношению к нему устойчивость и сопротивляемость. Таким образом, лечить ребенка с помощью антибиотиков можно только в соответствии с инструкциями педиатра и под его контролем.
То есть, нельзя урезать курс приема антибиотика, самовольно менять дозировку и, конечно, пропускать прием препарата.
Эхинацея.
shutterstock
Эхинацея, пожалуй, самая известная трава, произрастающая в восточной и центральной части Северной Америки. Ее листья, цветы и корни могут быть использованы в лечебных целях. Эхинацея отлично подходит для лечения инфекций, таких как простуда и грипп, а также других инфекций верхних дыхательных путей. Ее можно использовать для лечения:
- инфекции мочевыводящих путей;
- вагинальные дрожжевые инфекции;
- герпес;
- ВИЧ / СПИД;
- вирус папилломы человека (ВПЧ);
- инфекции крови (сепсис);
- тонзиллит;
- стрептококковые инфекции;
- сифилис;
- тиф;
- малярия;
- инфекции уха;
- свиной грипп;
- бородавки;
- инфекции носа и горла (дифтерия).
Трава также работает против беспокойства, хронической усталости, ревматоидного артрита, мигрени и многих других заболеваний
К сожалению, очень немногие продукты на рынке эхинацеи на самом деле содержат травы, и большинство из них загрязнены мышьяком и свинцом , поэтому важно покупать травы только из авторитетных источников или выращивать самостоятельно
Вопрос-ответ
Что такое фотофармакология и как она работает?
Фотофармакология — это область науки, изучающая взаимодействие света с лекарственными веществами. Она основывается на принципе, что определенные молекулы могут изменять свои свойства под воздействием света, что позволяет активировать или деактивировать фармакологические эффекты. Это открывает новые возможности для целенаправленного воздействия на клетки и ткани, минимизируя побочные эффекты.
Какие преимущества имеет использование фотофармакологии в медицине?
Одним из главных преимуществ фотофармакологии является возможность локального и контролируемого воздействия на ткани. Это позволяет уменьшить системные побочные эффекты, так как лекарственные вещества активируются только в нужном месте и в нужное время. Кроме того, фотофармакология может улучшить эффективность лечения, позволяя использовать более низкие дозы препаратов.
Какие примеры применения фотофармакологии уже существуют?
На сегодняшний день фотофармакология находит применение в различных областях медицины, включая онкологию, дерматологию и неврологию. Например, в лечении рака используются фотоактивируемые препараты, которые активируются светом и уничтожают опухолевые клетки. Также исследуются методы лечения кожных заболеваний, где свет помогает активировать лекарственные вещества, улучшая их действие на пораженные участки кожи.
Советы
СОВЕТ №1
Изучите основы фотофармакологии, чтобы понимать, как свет влияет на фармакологические процессы. Это поможет вам лучше осознать, как различные длины волн могут активировать или ингибировать действие лекарств.
СОВЕТ №2
Обратите внимание на безопасность при использовании фототерапии. Убедитесь, что вы используете подходящие устройства и следуете рекомендациям специалистов, чтобы избежать возможных побочных эффектов.
СОВЕТ №3
Проводите эксперименты с различными источниками света и их спектрами, чтобы выяснить, какие из них наиболее эффективны для конкретных препаратов. Это поможет вам оптимизировать лечение и достичь лучших результатов.
СОВЕТ №4
Следите за новыми исследованиями в области фотофармакологии, так как это направление активно развивается. Новые открытия могут предложить вам более эффективные методы лечения и улучшить понимание взаимодействия света и лекарств.